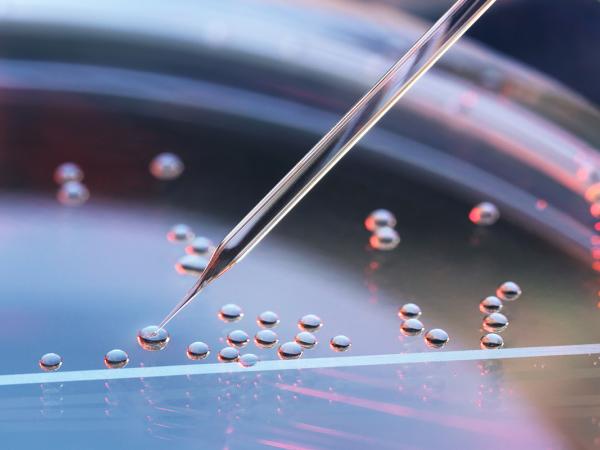
Service Intro Life Sciences MLS

How Federal Preemption, State AI Laws, and Chip Export Controls Will Shape US Policy
The 2026 AI policy environment is consolidating around two themes — competitiveness and national security — even as Washington debates federal preemption and states expand their own rules. Expect an assertive use of executive orders and agency action (including litigation strategies) alongside a patchwork of state laws that shape national compliance norms. At the same time, Congress is sharpening its focus on AI chips, export controls, and trade policy, positioning semiconductor strategy at the center of AI governance. For leaders, that adds up to a year of managed conflict: federal levers tightening while state mandates proliferate, with real implications for risk management, capital allocation, and product roadmaps.
Key points:
- National framework vs. preemption fight: Momentum builds for a federal AI framework amid concern that divergent state rules raise costs and weaken US competitiveness; scope, enforcement, and preemption remain contested.
- Executive branch leads: Following failed 2025 bills, the December 2025 Executive Order, “Ensuring a National Policy for Artificial Intelligence,” sets a low‑burden posture; agencies are expected to operationalize it in 2026.
- Enforcement architecture: A DOJ‑led AI Litigation Task Force is positioned to challenge certain state AI laws using existing federal statutes and regulations, yielding conflict management rather than clean preemption.
- State activity as de facto standard‑setting: New/expanded laws in California, Colorado, Texas, New York, and Florida — with California’s SB 53 viewed as a practical baseline — intensify multistate compliance demands.
- Chips and national security: Bipartisan energy behind the AI OVERWATCH Act would restrict exports of leading‑edge AI chips (e.g., Nvidia Blackwell) to foreign adversaries, with timelines meant to accelerate domestic capacity.
- Trade and tariffs: A January proclamation imposes targeted Section 232 tariffs on select advanced AI chip imports, framed as national security, while negotiations and investment incentives continue.
- Defense procurement focus: Accelerated acquisition, competition expansion, and strategic stockpiling aim to strengthen the domestic industrial base and supply chain resilience for AI‑critical inputs.
2026 AI Policy and Semiconductor Outlook
How Affordability, Data Centers, and Grid Constraints Will Shape Policy
Energy affordability is becoming the central political and policy concern of 2026 as the electric grid faces unprecedented load growth. Demand from data centers, manufacturing reshoring, and infrastructure improvements is straining both planning systems and regulatory frameworks. Nuclear power is reemerging as a strategic asset supported by expanded federal financing. Critical minerals policy is rapidly evolving into a full-scale industrial strategy. Regulatory uncertainty surrounding the Endangerment Finding and efficiency standards further complicates planning and investment for energy stakeholders. The resulting environment elevates reliability, cost control, and infrastructure buildout to the forefront of national competitiveness.
Key Points:
- Electricity demand in the US is climbing faster than in any recent period, creating new pressure on policymakers to prioritize stable monthly costs and reliable service for households and businesses.
- The rapid rise of data center construction is reshaping local and national conversations about energy supply, often becoming a focal point for concerns about grid strain, siting challenges, and future rate impacts.
- Nuclear energy is gaining fresh momentum as leaders look for firm and domestically sourced power that can support industrial growth, with federal financing programs playing an increasingly central role in bringing large projects forward.
- Grid expansion is becoming the defining constraint in US energy planning, as transmission planning, interconnection processes, and siting decisions determine how quickly new generation and large loads can be brought online.
- The entire system for sourcing and processing critical minerals is taking on new strategic importance, influencing decisions across manufacturing, defense, clean energy deployment, and grid buildout.
- Shifts in federal environmental and efficiency rules are creating a period of uncertainty in which companies must prepare for multiple regulatory outcomes, often adjusting investment plans and compliance approaches in real time.
2026 Energy Outlook
Affordability Pressures, TrumpRx, and ACA Uncertainty
Health care will be one of the most consequential policy arenas in 2026, driven by voter concerns over affordability, major federal initiatives such as TrumpRx, renewed debate over ACA premium subsidies, and the implementation of recently enacted Medicare and Medicaid extenders. With Congress navigating political pressures ahead of the midterms and agencies preparing a wave of regulatory guidance, organizations across the health care ecosystem face an environment defined by policy uncertainty, evolving cost‑control mechanisms, and heightened scrutiny of coverage and pricing decisions.
Key Points:
- Congress approves major health care extenders, triggering regulatory activity on Medicare, Medicaid, PBM oversight, telehealth extensions, and low‑income Part D supports.
- Reconciliation 2.0 proposals emerge, featuring market‑driven reforms, spending cuts, and policy riders that could reshape coverage, eligibility, and benefit design.
- TrumpRx launches, introducing a new transparency tool for lower‑cost medications and signaling the administration’s broader direction on drug pricing reform.
- ACA premium tax credit expiration raises affordability concerns, increasing pressure on Congress to stabilize the individual marketplace amid rising consumer costs.
- 2026 becomes a high‑stakes year for affordability, drug pricing, coverage stability, and midterm election positioning.
Read the Full 2026 Health Care Policy Analysis
The life sciences sector enters 2026 facing intensified executive pressure, rising trade uncertainty, and expanding national security oversight. With the administration leveraging pricing demands, potential tariffs, and BIOSECURE Act implementation to reshape industry behavior, companies must navigate an environment where regulatory risk, supply‑chain exposure, and federal funding shifts increasingly influence business strategy. At the same time, FDA user fee negotiations and evolving NIH grant distribution are setting the stage for longer‑term operational and competitive impacts.
Key Points
- Executive‑driven drug pricing pressure escalates, including TrumpRx’s launch and continued pushes for most‑favored‑nation pricing across manufacturers.
- Trade and tariff exposure grows, with potential Section 232 investigations targeting biomedical inputs, devices, and branded pharmaceuticals.
BIOSECURE Act implementation begins, triggering early industry decoupling from entities tied to national security risk lists ahead of 2026 ‑ 2027 compliance deadlines. - FDA user fee negotiations continue, with proposals touching on fees for non‑US companies, expanded AI use in review, and long‑term staffing needs.
NIH funding shifts reshape the research ecosystem, redistributing grants away from dominant institutions and increasing uncertainty across established life sciences hubs. - 2026 becomes a volatility year, defined more by executive action and enforcement tools than by legislative reform.
Read the Full 2026 Life Sciences Policy Outlook
How Infrastructure Funding, FAA Modernization, and Autonomous Vehicle Policy Will Shape the Sector
The transportation sector enters 2026 navigating major policy milestones, from Highway Trust Fund reauthorization to FAA modernization efforts and renewed congressional attention on autonomous vehicle regulation. With midterm election politics tightening the legislative calendar, the pace and scale of transportation investment will hinge heavily on White House engagement and congressional willingness to sustain infrastructure momentum. At the same time, AV policy activity, FAA system upgrades, and IIJA‑driven program decisions are shaping a pivotal year for stakeholders across transit, aviation, logistics, and mobility technologies.
Key Points
- Surface transportation reauthorization becomes a must‑pass priority, with the Highway Trust Fund expiring on September 30, 2026, prompting congressional negotiations on funding levels and IIJA program extensions.
- FAA modernization advances, following the $12.5 billion allocated in the reconciliation bill and the agency’s selection of a prime integrator to begin work on a new air traffic control system.
- Aviation funding needs continue to grow, with FAA and DOT leadership signaling that Congress may need to appropriate an additional $20 billion to complete modernization efforts.
- Autonomous vehicle regulation gains traction, as the House and Senate revisit the SELF DRIVE Act and consider expanding NHTSA’s authority to establish AV‑specific safety and cybersecurity requirements.
- Legislative timing is compressed by the midterms, increasing uncertainty around large‑scale spending decisions and putting added weight on presidential support for infrastructure priorities.
- 2026 becomes a decision‑heavy year, with outcomes likely to influence long‑term investment, innovation, and regulatory clarity across the transportation ecosystem.
Read the Full 2026 Transportation Policy Outlook
How Tax Reconciliation, Extenders, Tariffs, and Trade Reviews Will Shape Federal Policy
Tax and trade policy enters 2026 shaped by convergence between affordability pressures, geopolitical competition, and the limits of both reconciliation and executive authority. With Congress weighing targeted follow‑ups to the OBBBA, the expiration of select tax provisions, and emerging bipartisan proposals on digital assets and public finance, stakeholders face an environment defined by technical adjustments rather than sweeping reform. At the same time, tariff uncertainty, Ex‑Im reauthorization, and the first USMCA joint review introduce meaningful trade‑policy risk. Together these dynamics create a year where timing, political constraints, and careful calibration will matter as much as the substance of the policies themselves.
Key Points
- Reconciliation 2.0 remains possible but narrower, focused on targeted tax fixes, tariff‑funded rebates, capital gains adjustments, and select health‑related affordability provisions.
- Federal tax extenders resurface, with expired 2025 incentives including ACA premium tax credits and industry‑specific provisions potentially addressed later in the year.
- Bipartisan tax discussions continue, particularly around digital asset rules, refundable credits, and public finance proposals such as restoring advance refunding municipal bonds.
- Ex‑Im Bank reauthorization looms, with a December 31 deadline and debates over competitiveness, market distortion, and geopolitical positioning.
Tariff strategy faces political and legal uncertainty, including an anticipated Supreme Court ruling on presidential tariff authority and pressure from constituencies sensitive to costs. - USMCA undergoes its first joint review, raising questions around renewal, potential modernization, and North American cooperation in the context of broader competition with China.
- 2026 is a year of selective movement, where policy progress hinges on procedural limits, political timing, and incremental adjustments rather than large‑scale restructuring.
Read the Full 2026 Tax and Trade Policy Outlook